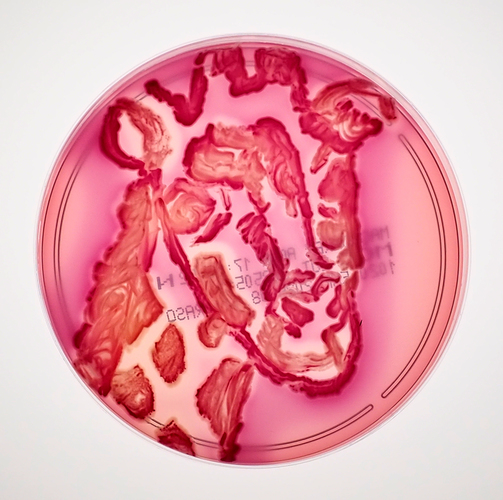

BIO-ART – spotkanie sztuki z biologią w GUMed
26.06.2025
Uczniowie II klasy Państwowego Liceum Sztuk Plastycznych im. Magdaleny Abakanowicz w Gdyni wzięli udział w wyjątkowych warsztatach BIO-ART, które odbyły się w Katedrze i Zakładzie Mikrobiologii Farmaceutycznej GUMed.
Dwudniowe zajęcia łączyły świat nauki i sztuki. Uczestnicy pracowali z mikroorganizmami – barwne szczepy bakterii, hodowane na podłożach agarowych, stały się żywą paletą i materiałem twórczym. Powstały niezwykłe kompozycje, które zyskiwały finalny wygląd dopiero po kilku dniach inkubacji.
Młodzież tworzyła z użyciem klasycznych ez mikrobiologicznych, a także cienkich pędzelków, co pozwalało na swobodniejsze, malarskie prowadzenie linii. Pracę uczniów wspierały trzy specjalistki z Katedry i Zakładu Mikrobiologii Farmaceutycznej GUMed – dr Jolanta Ficińska-Mazurczyk i dr Maria Bartoszewicz – dbając o merytorykę i bezpieczeństwo, a
pod okiem mgr Agaty Zygadło, absolwentki gdańskiej ASP, uczestnicy uczyli się także dokumentować swoje prace fotograficznie – zarówno w świetle dziennym, jak i UV, które ukazywało ukryte warstwy kompozycji.
Program został wzbogacony o wizytę w Ogrodzie Roślin Leczniczych, gdzie inż. Iza Kobierska z Katedry i Zakładu Farmakognozji opowiadała o właściwościach ziół i tradycjach zielarskich oraz spotkanie w Katedrze Toksykologii, prowadzone przez jej przedstawiciela, mgr. Wojciecha Rodzaja, który mówił o toksynach i badaniach nad ich wpływem na organizm człowieka.
Zwieńczeniem warsztatów było spotkanie z dr. hab. Krzysztofem Waleronem, kierownikiem Katedry Mikrobiologii GUMed, który przybliżył historię Uczelni i rozwój nauki w Gdańsku.
Jak mówią organizatorzy, BIO-ART to przykład, że nauka i sztuka nie muszą się wykluczać – mogą inspirować się nawzajem i wspólnie tworzyć nową jakość.
fot. Agata Zygadło
Archiwum
- Rok akademicki 2024/2025
- Rok akademicki 2023/2024
- Rok akademicki 2022/2023
- Rok akademicki 2021/2022
- Rok akademicki 2020/2021
- Rok akademicki 2019/2020
- Rok akademicki 2018/2019
- Rok akademicki 2017/2018
- Rok akademicki 2016/2017
- Rok akademicki 2015/2016
- Rok akademicki 2014/2015
- Rok akademicki 2013/2014
- Rok akademicki 2012/2013
- Rok akademicki 2011/2012
- Rok akademicki 2010/2011
- Rok akademicki 2009/2010
- Rok akademicki 2008/2009
- Rok akademicki 2007/2008
- Inauguracje roku akademickiego